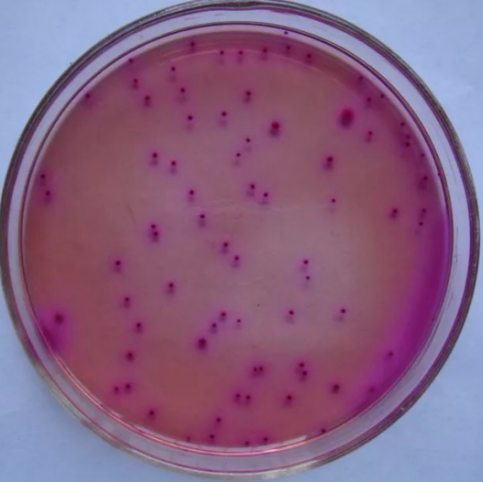
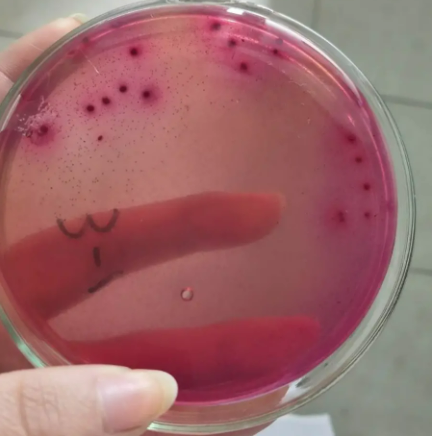

一、確定檢測方法
目前針對菌落總數(shù)測定的現(xiàn)行有效國家標(biāo)準(zhǔn)為:GB 4789.2-2016《食品安全國家標(biāo)準(zhǔn) 食品微生物學(xué)檢驗 菌落總數(shù)測定》(2022.12.30日廢止,2022版即將實施)
針對大腸菌群測定的現(xiàn)行有效國家標(biāo)準(zhǔn)有:GB/T 4789.3-2003《食品衛(wèi)生微生物學(xué)檢驗 大腸菌群測定》、GB 4789.3-2016《食品安全國家標(biāo)準(zhǔn) 食品微生物學(xué)檢驗 大腸菌群計數(shù)》大腸菌群兩種檢測方法;結(jié)果單位分別為:2003版—MPN/100g(mL);2016版—MPN計數(shù):MPN/g(mL);平板計數(shù)法 CFU/g(mL)。
可以根據(jù)食品標(biāo)準(zhǔn)或企業(yè)標(biāo)準(zhǔn)中的衛(wèi)生指標(biāo)確定大腸菌群的檢測方法。

如某企業(yè)生產(chǎn)雞粉調(diào)味料,行業(yè)標(biāo)準(zhǔn)中規(guī)定:大腸菌群(MPN/100g)≤150,則選用2003版的檢測方法;若單位為MPN/g(mL),則選用2016版MPN多管發(fā)酵法,若單位為CFU/g(mL),則選用2016版的平板計數(shù)法。
二、菌落總數(shù)的概念及衛(wèi)生意義
食品檢樣經(jīng)過處理,在一定條件下(如培養(yǎng)基、培養(yǎng)溫度和培養(yǎng)時間等)培養(yǎng)后,所得每g(mL)檢樣中形成的微生物菌落總數(shù)。
按國家標(biāo)準(zhǔn)方法規(guī)定,即在需氧情況下,37℃培養(yǎng)48h,能在平板計數(shù)瓊脂培養(yǎng)基上生長的細(xì)菌菌落總數(shù),所以厭氧或微需氧菌、有特殊營養(yǎng)要求的以及非嗜中溫的細(xì)菌,由于現(xiàn)有條件不能滿足其生理需求,故難以繁殖生長。
因此,菌落總數(shù)并不表示實際中的所有細(xì)菌總數(shù),也不能區(qū)分其中細(xì)菌的種類,所以有時被稱為雜菌數(shù)或需氧菌數(shù)。
三、菌落總數(shù)的測定
菌落總數(shù)的常規(guī)檢驗方法菌落總數(shù)的常規(guī)檢驗方法(GB4789.2-2016):
基本操作一般包括:樣品的稀釋——傾注平皿——培養(yǎng)48小時——計數(shù)報告。

四、菌落總數(shù)的計數(shù)
根據(jù)菌落形成單位(CFU)進(jìn)行計數(shù),簡單來說就是數(shù)平板上長了多少個小圓點(可添加0.1%TTC在平板計數(shù)瓊脂中,菌落呈紅色,更方便計數(shù)),菌落生長狀況大體可以分為四種情況:
無蔓延菌落
這種情況的菌落計數(shù)可以直接數(shù)小圓點,低于30CFU的平板記錄具體菌落數(shù),大于 300CFU的可記錄為多不可計。

片狀菌落
這種情況下不宜采用,若兩個平行平板都出現(xiàn)片狀菌落需重做實驗。

半片狀半無蔓延菌落
若片狀菌落不到平板的一半,而其余一半中菌落分布又很均勻,即可計算半個平板菌落后乘以2,代表一個平板菌落數(shù)。

半片狀半無蔓延菌落
若片狀菌落不到平板的一半,而其余一半中菌落分布又很均勻,即可計算半個平板菌落后乘以2,代表一個平板菌落數(shù)。

五、大腸菌群的概念及衛(wèi)生意義
大腸菌群并非細(xì)菌學(xué)分類命名,而是衛(wèi)生細(xì)菌領(lǐng)域的用語,它不代表某一個或某一屬細(xì)菌,而指的是具有某些特性的一組與糞便污染有關(guān)的細(xì)菌,這些細(xì)菌在生化及血清學(xué)方面并非完全一致,其定義為:需氧及兼性厭氧、在37℃能分解乳糖產(chǎn)酸產(chǎn)氣的革蘭氏陰性無芽胞桿菌。
一般認(rèn)為該菌群細(xì)菌可包括大腸埃希氏菌、檸檬酸桿菌、產(chǎn)氣克雷白氏菌和陰溝腸桿菌等。
對于4789.3-2016MPN計數(shù)法中:
推測試驗:樣品稀釋后,選擇三個稀釋度,每個稀釋度接種三管LST肉湯。36±1℃培養(yǎng)48±2h,觀察是否產(chǎn)氣。
證實試驗:將產(chǎn)氣管培養(yǎng)物接種煌綠乳糖膽鹽(BGLB)肉湯管中,36±1℃培養(yǎng)48±2h,觀察是否產(chǎn)氣。以BGLB產(chǎn)氣為陽性。查MPN表,報告每ml(g)樣品中大腸菌群的MPN值。
為方便大家使用和觀看,為大家總結(jié)MPN法檢驗大腸菌群的流程如下:




對于4789.3-2016平板計數(shù)法中平板菌落數(shù)的選擇:
典型菌落為紫紅色,菌落周圍有紅色的膽鹽沉淀環(huán),菌落直徑為0.5mm或更大。
可疑大腸菌群菌落,部分符合典型菌落特征的菌落,比如以下平皿中

1、紫紅色圓形菌落,菌落周圍有透明圈;
2、紫紅色梭型菌落,菌落較小菌落周圍無沉淀圈,都算是可疑大腸菌群菌落。
按比例挑取10個不同類型的典型和可疑菌落,少于10個菌落的挑取全部典型和可疑菌落。假如在1:10的平板上可疑大腸菌群有10個,典型大腸菌群有6個,證實實驗應(yīng)該按照可疑跟典型5:3的比例進(jìn)行挑取,移種于BGLB肉湯管內(nèi)。
六、訂購信息
